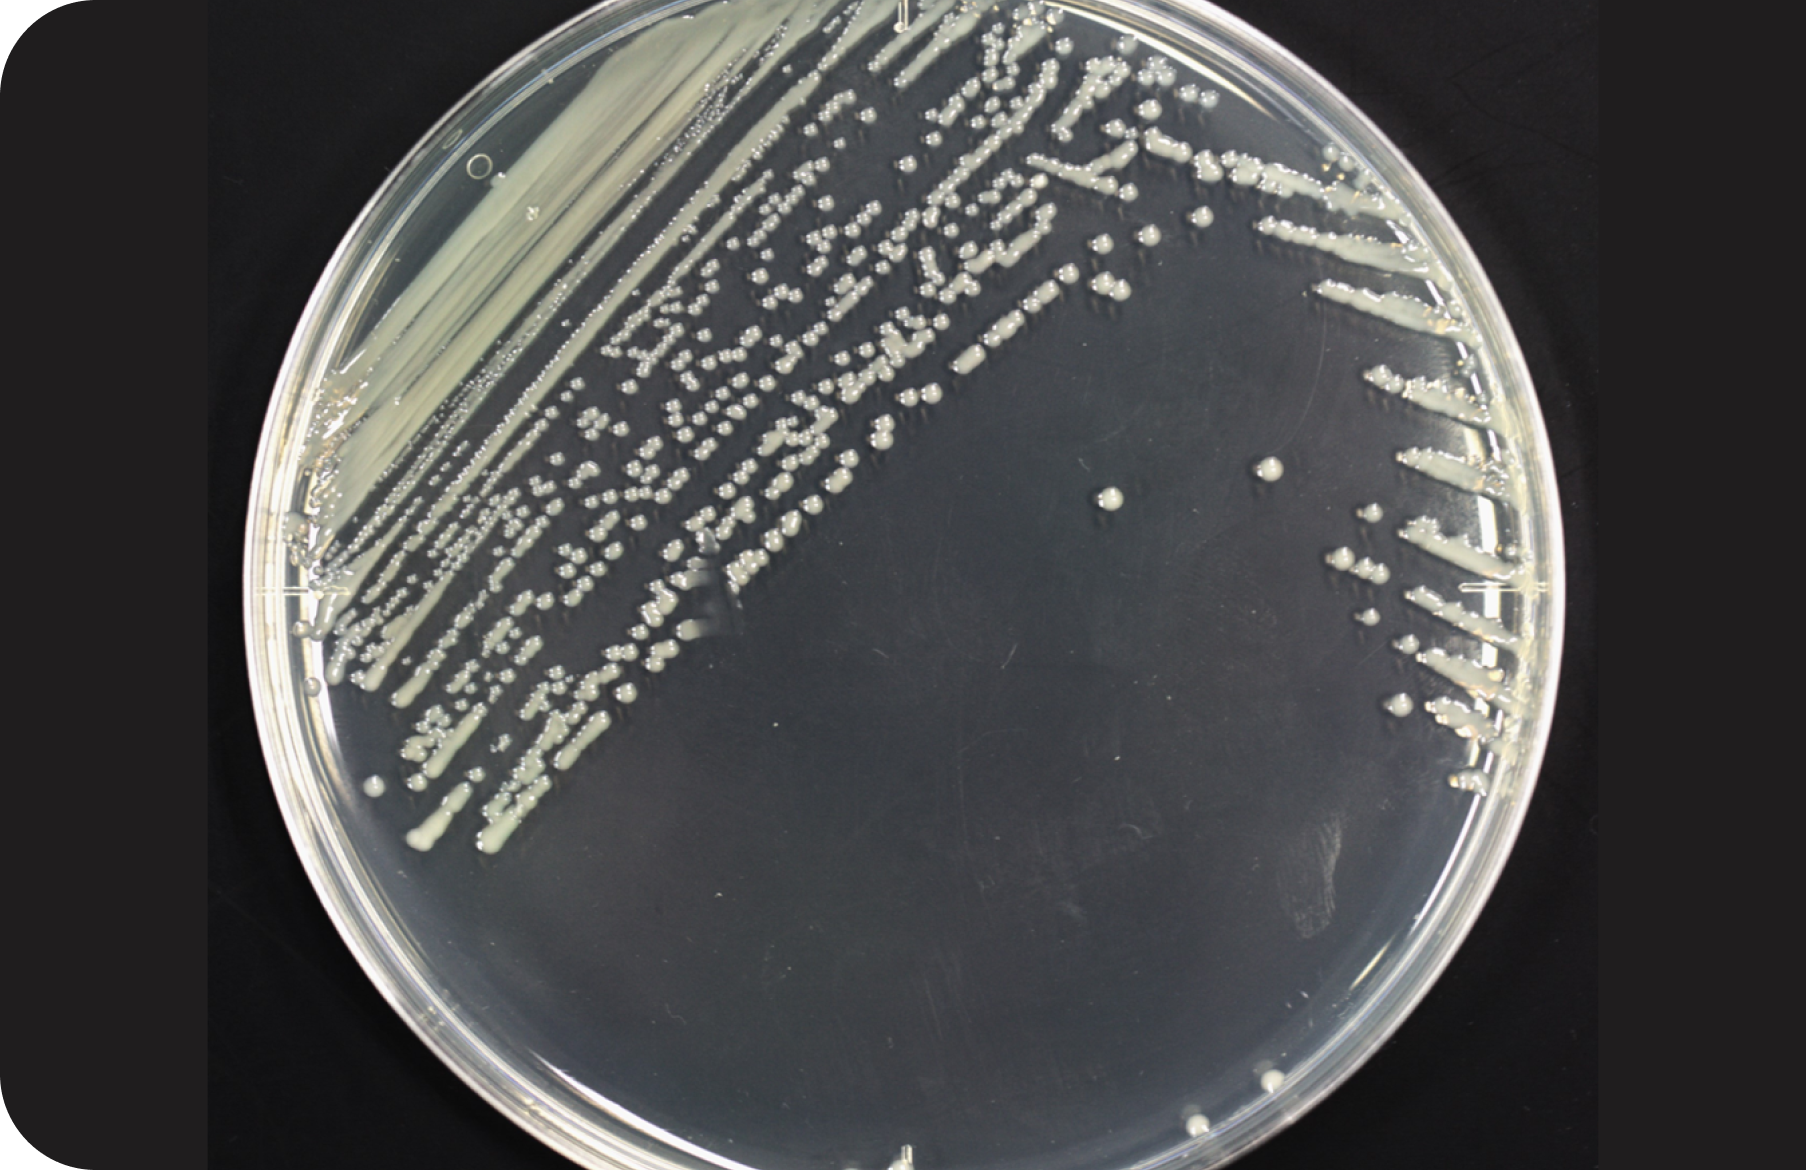

TOP
トップ
























学術変革領域研究 (B) 令和7〜9年度
あらゆる細菌の遺伝子組換えを可能とするユニバーサル形質転換


A01班
生体膜構造制御と
ナノバイオ材料から目指す
ユニバーサル形質転換
A02班
アンチセンス核酸による
細菌遺伝子発現制御で目指す
ユニバーサル形質転換
A03班
生体膜構造制御と
ナノバイオ材料から目指す
ユニバーサル形質転換
総括班
あらゆる細菌の
遺伝子組換えを可能とする
ユニバーサル形質転換













本領域では、細菌分子生物学(A01班)に加え、核酸化学(A02班)とナノバイオ材料工学(A03班)の技術を組み合わせることで、ユニバーサル形質転換の実現を目指します。自然界では外来DNAの侵入と複製を、実験室では組換えDNAによる形質転換を妨げている細菌のファイアウォールを突破するための基礎研究と技術開発を行います。
領域概要